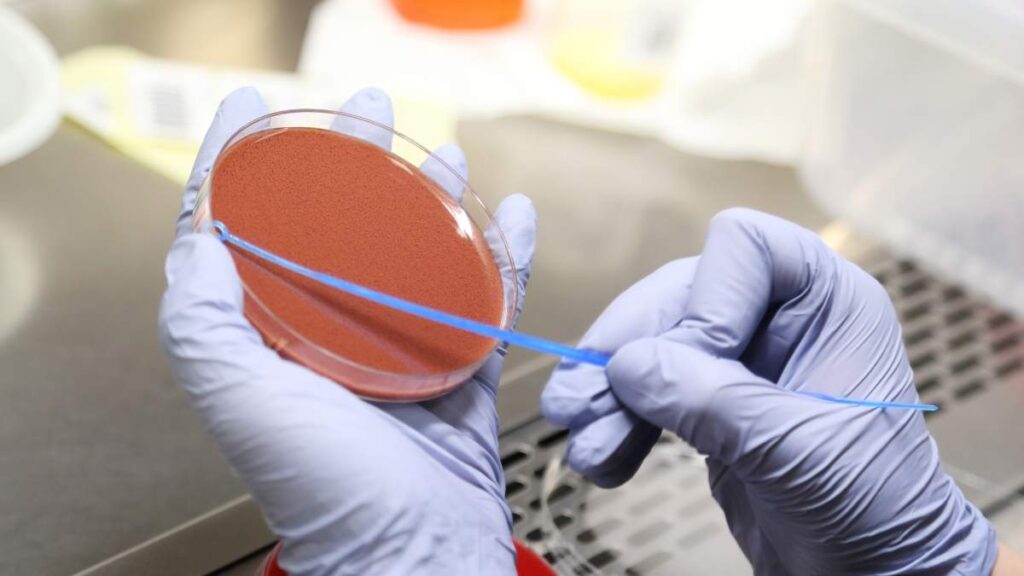

Bacteria in urine
The presence of bacteria in the urine, known in medicine as bacteriuria or bacteria, is a signal that can cause concern. It is often the first indicator of a urinary tract infection (UTI), but it does not always mean a disease that requires immediate treatment. Understanding what this urine test result means, what its causes are, when to worry, and when observation is enough is crucial for kidney and bladder health.
Table of contents
What exactly does the presence of bacteria in urine mean?
The urinary system, which includes the kidneys, ureters, bladder and urethra, is physiologically sterile above the urethral sphincter. This means that in the right situation, there should be no microorganisms in it. Bacteria in the urine appear when microorganisms, most often from the final section of the digestive tract, enter the urethra and then travel up to the bladder.
The most common culprit is Escherichia coli, or Escherichia coli, and is one of the most common bacteria present in urinary tract infections. (E. coli), which is responsible for 70-95% of all cases of uncomplicated urinary tract infections. Other bacteria that can cause infections include, m.in, Staphylococcus saprophyticus, Klebsiella pneumoniae, Proteus mirabilis or Enterococcus faecalis.
The key concept in diagnostics is the illustrious bacteriuria. It means that a number of bacteria is found in a urine sample that indicates an actual infection, and not contamination of the sample during collection. The criteria for the diagnosis of a significant bacteriuria, depending on the method of urine collection and clinical symptoms, which we will discuss in detail in the section on diagnostics.
Asymptomatic bacteriuria – a silent tenant who is not always an enemy
Asymptomatic (or asymptomatic) bacteriuria is a condition in which numerous bacteria are present in the urine (found in a culture), but the patient does not experience any typical symptoms of a urinary tract infection, such as pain when peeing, pollakiuria or fever.
This may sound surprising, but in many cases, this condition can lead to a urine test that indicates the presence of bacteria. does not require antibiotic treatment. The body often maintains balance on its own, and unnecessary antibiotic therapy could lead to the development of drug resistance of bacteria and disruption of the natural microflora.
Who is most often affected by asymptomatic bacteriuria?
- Elderly.
- Postmenopausal women.
- Patients with a catheter permanently inserted into the bladder.
- People with diabetes may be more likely to get urinary tract infections.
When does asymptomatic bacteriuria need to be treated?
However, there are two key situations in which treatment for asymptomatic bacteriuria is absolutely necessary:
- Pregnancy: In pregnant women, even the asymptomatic presence of bacteria in the urine poses a serious risk. It can lead to acute pyelonephritis in the mother, and also increases the risk of premature birth and low birth weight of the baby. That is why every pregnant woman has a routine urine test.
- Before planned urological procedures: Elimination of bacteria from the urinary tract is essential to minimize the risk of dangerous postoperative complications, such as urosepsis (a systemic infection originating in the urinary tract).
Urinary tract infection (UTI) – when bacteria cause illness
When bacteria multiplying in the urinary tract cause inflammation and cause characteristic ailments, we speak of a urinary tract infection. Symptoms depend on the location of the infection.
Cystitis
This is the most common form of UTI, affecting the lower urinary tract. It is extremely troublesome, but usually does not pose a serious health risk, as long as it is treated early enough.
Typical symptoms of cystitis:
- Pain or burning sensation when urinating (dysuria): This is the most characteristic symptom.
- Pollakyuria may be a symptom of a urinary tract infection. The need to go to the toilet all the time, even if the bladder is almost empty.
- Urgency may be the result of a urinary tract infection. A violent, difficult to control need to urinate.
- Pain in the lower abdomen, above the pubic symphysis.
- Change in the appearance and smell of urine: This may be a symptom of the presence of individual bacteria in the sample. It can become cloudy, darker, with an unpleasant, intense smell.
- Hematuria (hematuria): The presence of blood in the urine, which may color it pink or red.
Pyelonephritis
This is a much more serious condition in which the infection from the bladder reaches the kidneys. It requires urgent medical intervention, because if left untreated, it can lead to permanent kidney damage, abscesses and even sepsis.
Symptoms that may indicate kidney involvement:
- High fever (above 38°C) and chills.
- A dull, excruciating pain in the lumbar region, on one or both sides of the back.
- Nausea and vomiting.
- General malaise, weakness.
- Symptoms typical of cystitis may or may not co-occur.
Causes and risk factors – why do I have bacteria in my urine?
There are many factors that promote the penetration and multiplication of bacteria in the urinary tract.
- Gender: Women suffer from UTI much more often than men. This is due to the anatomical structure – the shorter urethra (about 4 cm) and its close proximity to the anus make it easier for bacteria to migrate.
- Sexual activity: During sexual intercourse, bacteria from the perineal area can be mechanically introduced into the urethra, which increases the risk of urinary tract infection.
- Improper intimate hygiene: Rubbing yourself in the direction from the anus to the urethra promotes the transmission of E. coli bacteria.
- Menopause can affect the risk of urinary tract infections. Hormonal changes (estrogen deficiency) lead to changes in the vaginal microflora and atrophy of the urethral mucosa, which weakens the natural protective barriers.
- Urinary outflow disorders: Anything that makes it difficult to empty the bladder completely creates ideal conditions for bacteria. Examples include:
- Benign prostatic hyperplasia (BPH) in men.
- Kidney stones.
- Anatomical defects of the urinary tract.
- Bladder catheterization: Catheter insertion is one of the most common causes of nosocomial infections.
- Weakened immunity: Diabetes, immunosuppressive treatment or autoimmune diseases increase susceptibility to infections.
- Pregnancy: Hormonal changes and the pressure of the enlarging uterus on the ureters promote urinary stagnation and infections.
Diagnostics – how to detect and identify the enemy?
The basis for diagnosis is the analysis of a urine sample. For the result to be reliable, it is crucial to collect it correctly.
How to properly collect a urine sample for testing?
Errors at this stage are the most common cause of false results, indicating the presence of bacteria that are not present in the bladder at all.
- Get a sterile container from the pharmacy.
- Take a sample in the morning, from the first voiding after the night, because the urine is the most concentrated then.
- Wash your hands thoroughly with soap and water.
- Wash the area around the urethral orifice with soap and water (women from front to back), then dry with a disposable towel.
- Collect urine from the so-called midstream urine for more accurate results. “middle stream” : Start urinating into the toilet, then without interrupting the stream, base the container and fill it to about half. Also return the final portion of urine to the toilet.
- Close the container tightly, trying not to touch its inner walls.
- Deliver the sample to the laboratory as soon as possible, preferably within 1-2 hours, to minimize the risk of bacteria multiplying in the sample. If this is not possible, store it in the refrigerator.
General urinalysis
This is a basic, rapid screening test. In the context of infection, the following are mainly assessed:
- Presence of nitrites: Some bacteria (including E. coli) convert nitrates present in urine into nitrites. Their presence strongly suggests a bacterial infection.
- Leukocyte (white blood cell) count: Elevated levels (leukocyturia) indicate inflammation in the urinary tract.
- Presence of bacteria: The laboratory technician assesses under a microscope whether bacteria are visible in the urine sediment (described as “numerous”, “quite numerous”, “single”).
Urine culture and antibiogram – the gold standard
When a general examination suggests an infection or when symptoms are severe, the doctor orders a urine culture. This test allows bacteria to be detected in a urine sample and appropriate treatment to be determined.
- Accurate identification of the species of bacteria that caused the infection.
- Determination of its amount in 1 ml of urine (CFU/ml – colony-forming units).
Interpretation of the culture result (significant bacteriuria):
- ≥ 10^5 CFU/ml: In women with symptoms of cystitis or in the case of asymptomatic bacteriuria.
- ≥ 10^4 CFU/ml is the norm indicating a high amount of bacteria in the urine. In women with symptoms of pyelonephritis, it is important to perform a urine culture test to identify the causes and symptoms of infection.
- ≥ 10^3 CFU/ml: In men with UTI symptoms or in urine collected by catheterization.
Together with the culture, an antibiogram is performed. It is a test that determines which antibiotics the identified bacteria is sensitive to and which it is resistant to. This is an invaluable tip for the doctor, allowing him to choose the most effective targeted therapy.
Treatment – how to get rid of bacteria from urine?
The method of treatment depends on whether we are dealing with asymptomatic bacteriuria or a full-blown urinary tract infection.
Antibiotic therapy – the basis of UTI treatment
In the case of symptomatic urinary tract infection, antibiotic treatment is a must to reduce the number of bacteria in the urine.
- First-line treatment: In uncomplicated cystitis, over-the-counter drugs are often used (in Poland, e.g. furazidine, i.e. popular furagin) or short treatments with antibiotics prescribed by a doctor (e.g. treatment of urinary tract infections) can be effective. cotrimoxazole, trimethoprim, fosfomycin).
- Targeted treatment: If a culture with an antibiogram has been performed, the doctor will select the antibiotic that is most likely to fight a specific strain of bacteria.
- Treatment of pyelonephritis: It requires stronger antibiotics (often from the fluoroquinolone or cephalosporin group) and longer treatment (10-14 days), and in more severe cases even hospitalization and intravenous drug administration.
The most important rule: Always complete the full course of antibiotics prescribed by your doctor, even if your symptoms disappear sooner! Discontinuation of treatment may result in a recurrence of the infection and the development of bacterial resistance.
Supportive treatment and home remedies
These methods will not replace an antibiotic to treat an active infection, but they can significantly relieve symptoms and speed up recovery.
- Intensive hydration: This is an absolute must. Drinking plenty of water (2-3 liters a day) helps to flush bacteria out of the bladder.
- Pain relievers and anti-inflammatory medications: can help relieve symptoms associated with urination. Paracetamol or ibuprofen can help relieve bladder pain and discomfort.
- Hottie: Warm compresses on the lower abdomen can relax the muscles and reduce pain.
- Cranberry: Cranberry supplements (preferably in the form of an extract with a high content of proanthocyanidins – PAC) can make it difficult for bacteria to adhere to the walls of the bladder. It works mainly preventively, but can be used as a support.
- Vitamin C: It acidifies the urine, which can create an unfavorable environment for some bacteria.
- Avoiding irritation: During the infection, it is worth giving up carbonated drinks, alcohol, hot spices and coffee, which can irritate the bladder and increase the symptoms associated with urination.
Prevention – how to prevent the recurrence of infections?
If you tend to have recurring UTIs, it is crucial to implement habits that will reduce the risk of subsequent episodes.
- Drink plenty of fluids, mainly water, which are important for maintaining the correct amount of bacteria in your urine.
- Do not hold urine. Go to the toilet regularly and always empty your bladder completely.
- Urinate after each sexual intercourse to flush out any bacteria that may have entered the urethra.
- Take care of intimate hygiene. Use mild liquids, always wipe yourself in the direction from front to back.
- Wear airy, cotton underwear. Avoid tight pants and thongs.
- Consider using cranberry or D-mannose supplements as a preventative measure to reduce your risk of urinary tract infections.
- In postmenopausal women , topical estrogen therapy prescribed by a gynaecologist may be effective.
- In the case of recurrent infections , your doctor may recommend taking a low dose of antibiotics for a long period of time.
Summary
Bacteria in urine is a signal that should not be ignored, but should be interpreted wisely. In many cases, as in asymptomatic bacteriuria in people outside risk groups, this is not a reason to panic. However, when symptoms appear – pain, burning, pollakiuria – it is necessary to consult a doctor and implement appropriate treatment to prevent dangerous complications, such as pyelonephritis. Proper diagnosis based on general examination and urine culture, combined with targeted antibiotic therapy and preventive measures, is the key to maintaining the health of the urinary tract. Remember about regular hydration and good hygiene habits – these are the simplest and most effective weapons in the fight against unwanted bacteria.


